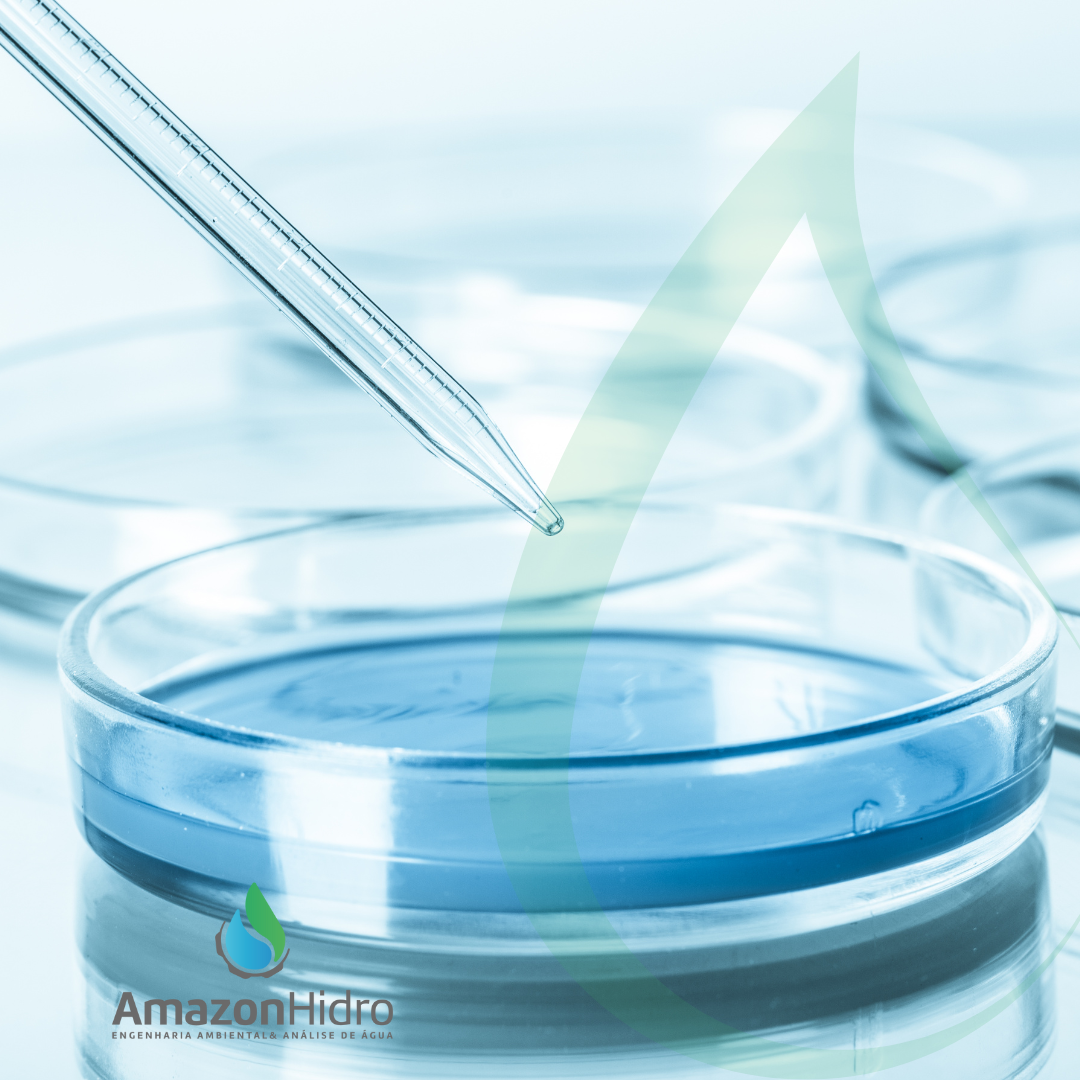

Laboratório de Análise de Água e Efluentes:
Análise de Qualidade da Água
- Análises de águas superficiais
- Análises águas subterrâneas
- Análise de água para consumo humano
- Análises de águas de processos industriais
- Análise de água para irrigação
- Análise de água para piscicultura
- Análise de água de piscina